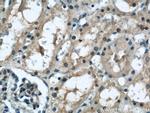
TAX1BP3 Antibody in Immunohistochemistry (Paraffin) (IHC (P))

Search
Proteintech
TAX1BP3 Polyclonal Antibody
{{$productOrderCtrl.translations['antibody.pdp.commerceCard.promotion.promotions']}}
{{$productOrderCtrl.translations['antibody.pdp.commerceCard.promotion.viewpromo']}}
{{$productOrderCtrl.translations['antibody.pdp.commerceCard.promotion.promocode']}}: {{promo.promoCode}} {{promo.promoTitle}} {{promo.promoDescription}}. {{$productOrderCtrl.translations['antibody.pdp.commerceCard.promotion.learnmore']}}
产品信息
11692-1-AP
种属反应
已发表种属
宿主/亚型
分类
类型
抗原
偶联物
形式
浓度
规格
纯化类型
保存液
内含物
保存条件
运输条件
产品详细信息
Immunogen sequence: MSYIPGQPV TAVVQRVEIH KLRQGENLIL GFSIGGGIDQ DPSQNPFSED KTDKGIYVTR VSEGGPAEIA GLQIGDKIMQ VNGWDMTMVT HDQARKRLTK RSEEVVRLLV TRQSLQKAVQ QSMLS (1-124 aa encoded by BC023980)
靶标信息
May regulate a number of protein-protein interactions by competing for PDZ domain binding sites. Binds CTNNB1 and may thereby act as an inhibitor of the Wnt signaling pathway. Competes with LIN7A for KCNJ4 binding, and thereby promotes KCNJ4 internalization. May play a role in the Rho signaling pathway. May play a role in activation of CDC42 by the viral protein HPV16 E6.
仅用于科研。不用于诊断过程。未经明确授权不得转售。
生物信息学
蛋白别名: C20orf100; GCX1; GIP-3; Glutaminase-interacting protein 3; Tax interaction protein 1; Tax-interacting protein 1; Tax1 (human T-cell leukemia virus type I) binding protein 3; Tax1 binding protein 3; Tax1-binding protein 3; tax1bp3; tax1bp3 {ECO:0000312|EMBL:AAH97976.1}; TIP-1; unnamed protein product
基因别名: 1300011C24Rik; TAX1BP3; TIP-1; TIP1
UniProt ID: (Human) O14907, (Mouse) Q9DBG9, (Rat) Q4QQV1
Entrez Gene ID: (Human) 30851, (Mouse) 76281, (Rat) 360564